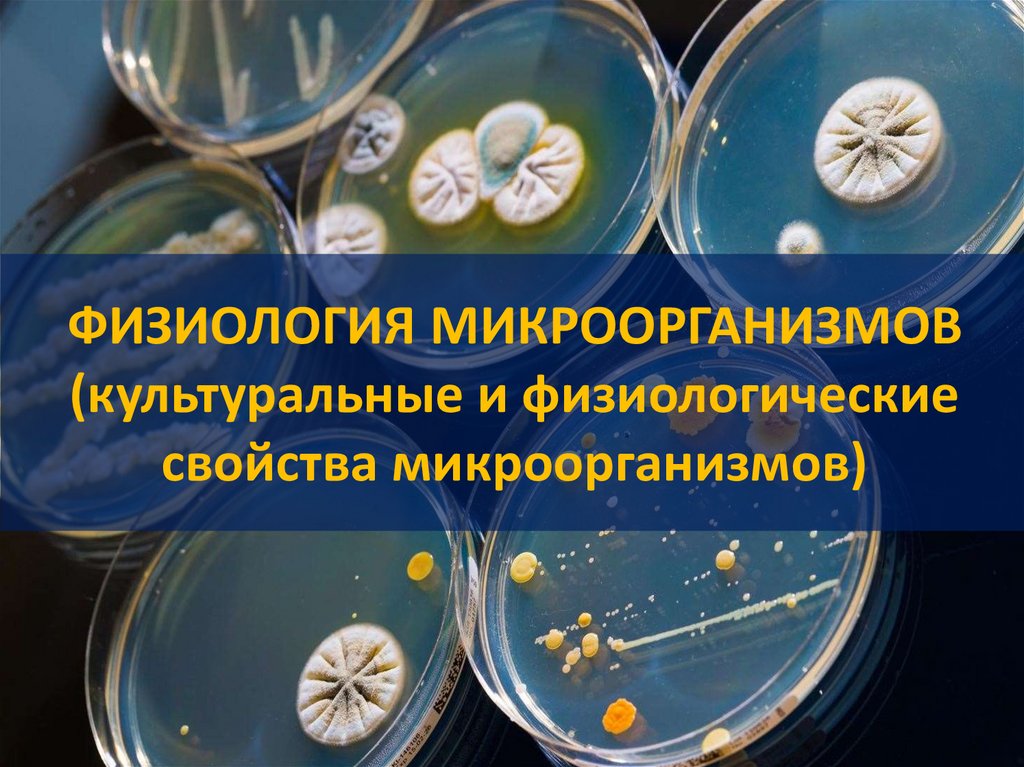
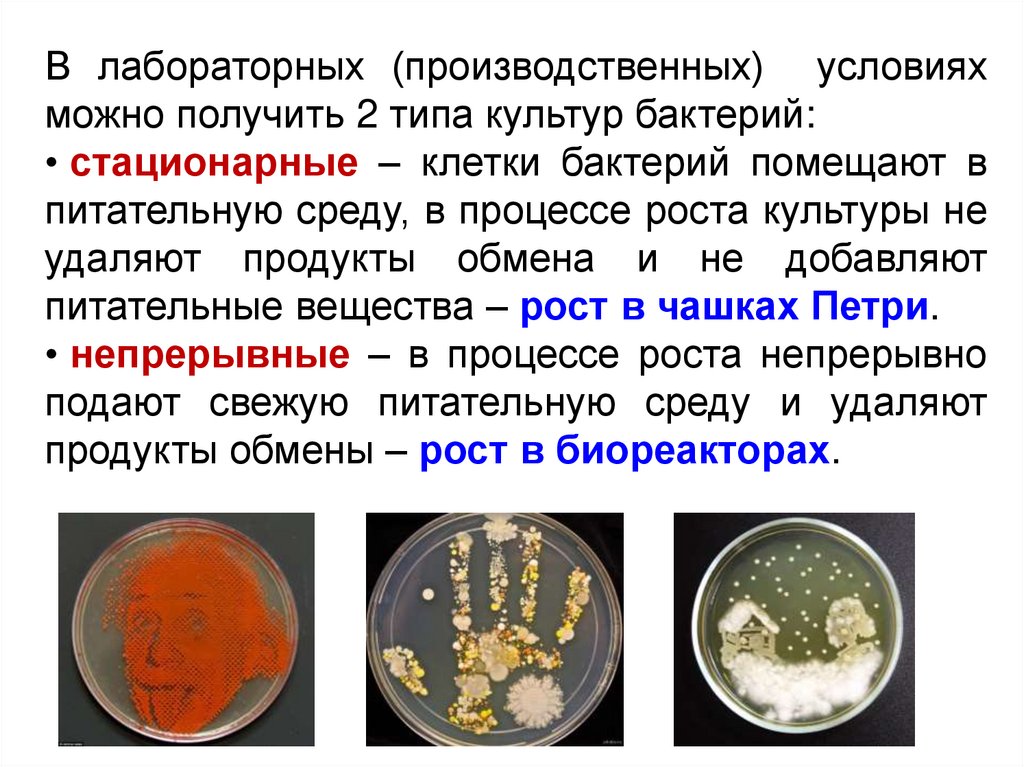

Similar presentations:
Физиология микроорганизмов (культуральные и физиологические свойства микроорганизмов)
1. Индикация вирусов в культуре клеток
1) Цитопатическое действие (ЦПД) – видимые подмикроскопом морфологические изменения клеток:
• слияние клеток с образованием синцития (вирус кори);
• сморщивание и деструкция клеток (энтеровирусы);
• агрегация клеток (аденовирусы);
• зоны лизиса в монослое (ЦМВ).
2. 2) Образование симпластов
ЦПД вируса кори на клетки Vero: образование гигантскихмногоядерных клеток - симпластов, с последующей
деструкцией и формированием крупных полостей типа
"мыльных пузырей".
Интактные
клетки
линии
Vero
ЦПД
вируса
кори в
культуре
клеток
Vero
3.
3) Вирусные включения –скопление вирусных частиц
или отдельных компонентов
вирусов в цитоплазме или
ядре клеток, выявляемые
под микроскопом при
специальном окрашивании.
• Вирусы герпеса,
аденовирусы, гриппа,
бешенства, оспы и др.
4. 4) Образование бляшек
• бляшки (негативные колонии)– ограниченные участки,
состоящие из дегенеративных
клеток, которые
вирусы образуют в монослое
клеток
• одна бляшка соответствует
потомству одного вириона
• титр вируса
выражают числом
бляшкообразующих
единиц (БОЕ) в 1 мл
5.
5) Гемадсорбция –способность культур
клеток,
инфицированных
вирусами,
адсорбировать на
своей поверхности
эритроциты.
6.
6. «Цветная» проба: живые клетки в процессеметаболизма → кислые продукты → изменение
рН среды и цвета индикатора фенолового
красного на желтый.
При продукции вирусов нормальный метаболизм
клеток нарушается, клетки гибнут, и среда
сохраняет свой первоначальный (красный)
цвет.
7. ФИЗИОЛОГИЯ МИКРООРГАНИЗМОВ (культуральные и физиологические свойства микроорганизмов)
8.
• ФИЗИОЛОГИЯМИКРООРГАНИЗМОВ –
раздел микробиологии,
изучающий
жизнедеятельность
микробов, процессы их
питания,
обмена,
дыхания,
роста,
размножения,
закономерности
взаимодействия
с
окружающей средой.
Воспроизведение
потомства
Собственное
воспроизведение
Обеспечение
жизненных
функций
9. ЗНАЧЕНИЕ ФИЗИОЛОГИИ МИКРООРГАНИЗМОВ
•Физиологическиеи
биохимические
особенности
микроорганизмов положены в основу их систематики.
1
2
•Важны для изучения механизмов патогенного действия,
культивирования, дифференцировки и идентификации
отдельных микроорганизмов.
3
•Для разработки биотехнологии производства вакцин,
антибиотиков и других биологически активных продуктов.
4
•Для понимания патогенеза, постановки микробиологического
диагноза, проведения лечения и профилактики инфекционных
заболеваний, регуляции взаимоотношений человека с
окружающей средой и т.д.
10. Основу жизнедеятельности микроорганизмов составляет обмен веществ (метаболизм).
• Конструктивный обмен (питание)• Энергетический процесс (дыхание)
• Конечный продукт обмена веществ выделяется во
внешнюю среду.
• Особенностью микробов является необычайно
интенсивный обмен веществ. Основная часть
пищи расходуется в энергетическом обмене (т.е.
питательные вещества в основном расщепляются с целью получения энергии
и мало тратится на строение собственной клетки), при котором
выделяется большое количество продуктов обмена.
11. Поступление питательных веществ в клетку
Виды транспорта• Поступление веществ и воды происходит через всю поверхность
клетки.
• Поступающие вещества могут входить только в растворенном
состоянии.
Простая диффузия
По градиенту концентрации без затрат
энергии (Молекулы воды, некоторых
газов (молекулярного кислорода, азота,
водорода), некоторые ионы)
Облегченная
диффузия
По градиенту концентрации с помощью
белков-переносчиков
(моносахара,
аминокислоты). Выход продуктов обмена.
Активный транспорт
С затратой энергии против
градиента концентрации
12. Транспорт питательных веществ в клетку
Без затрат энергии(по градиенту
концентрации)
Простая
диффузия
Облегченная
диффузия
С использованием энергии
(против градиента
концентрации)
13. 1. ПИТАНИЕ Классификация микроорганизмов по типу питания
ПО ИСТОЧНИКАМ УГЛЕРОДААутотрофы
органические вещества синтезируют из
неорганических (СО2)
Гетеротрофы (сапрофиты, паразиты)
используют готовые органические соединения, такие
как углеводы, спирты, аминокислоты, органические
кислоты.
В ЗАВИСИМОСТИ ОТ ОКИСЛЯЕМОГО СУБСТРАТА
Литотрофы
(организмы, для которых донорами электронов,
необходимых для процессов биосинтеза или
запасания энергии через аэробное или анаэробное
дыхание, являются неорганические вещества)
(железобактерии, нитрифицирующие бактерии)
Органотрофы
доноры электронов - органические вещества
(стрептококки, стафилококки)
ПО ИСТОЧНИКУ ЭНЕРГИИ
Фототрофы (фотосинтезирующие)
энергия света
(пурпурные и зеленые бактерии, цианобактерии)
Хемотрофы
(за счет окислительно-восстановительных
реакций)
ПО ОТНОШЕНИЮ К ФАКТОРАМ РОСТА
Ауксотрофы (не способны синтезировать определенные
органические вещества, ассимилирующие их в готовом виде из
окружающей среды, нуждаются в факторах роста)
Прототрофы (способны сами
синтезировать органические
вещества)
14. ПРИМЕРЫ
• Фотолитоавтотрофы – водоросли, цианобактерии(цианеи), пурпурные серные бактерии
• Фотоорганогетеротрофы – пурпурные несерные
бактерии
• Хемоорганогетеротрофы – большинство бактерий
(в том числе патогенные и условно-патогенные),
простейшие, грибки
• Хемолитоавтотрофы – некоторые сапрофитные
бактерии
15.
Прототрофы – не нуждаются в дополнительныхфакторах роста.
Ауксотрофы – не растут на питательных средах без
добавления факторов роста.
Факторы роста – чаще витамины, аминокислоты,
азотистые основания. Их источник – чаще всего
дрожжевой автолизат
Олиготрофы – растут
только при низких
концентрациях питательных веществ (от долей
до 100мг/л).
Копиотрофы – растут при высокой концентрации
питательных веществ (1-100г/л.)
16. Классификация микроорганизмов
По источнику углеродаАвтотрофы
Гетеротрофы
СО2
органические соединения
По источнику энергии
Фототрофы
свет
В зависимости от донора
электронов
Литотрофы
Хемотрофы
Энергия химических связей
Органотрофы
получают питательные вещества от
макроорганизма
питаются мертвым органическим материалом и
независимы от других организмов
17. Питание бактерий
18.
19.
• Микроорганизмы не способны усваивать твердыевещества, поэтому они превращают их в доступное
состояние с помощью органических кислот, выделяемых
за пределы клетки, и ферментов.
• Однако некоторые субстраты не растворяются в воде
(белки, полисахариды), или образуют коллоидные
растворы, которые не проникают в клетку.
• В таком случае клеточные экзоферменты, которые
выделяются в окружающую среду, вызывают гидролиз
этих субстанций, расщепляя их к более простым и мелким
молекулам и переводя в растворимое состояние.
20.
Эндоферменты катализируют метаболизм, проходящийвнутри клетки.
Экзоферменты выделяются клеткой в окружающую среду,
расщепляя макромолекулы питательных субстратов до простых
соединений, которые усваиваются клеткой.
Могут инактивировать антибиотики (пенициллиназа и др.),
выполняя защитную функцию.
Различают:
● конститутивные ферменты - синтезируются непрерывно,
независимо от наличия в питательной среде соответствующего
субстрата;
● индуцибельные (адаптивные) ферменты - синтезируются
только при наличии в среде субстрата данного фермента
(например, β-галактозидаза кишечной палочкой на среде с
глюкозой практически не образуется, но увеличивается при
выращивании палочек на среде с лактозой).
21. 2. Дыхание
• Дыхание – процесс биологическогоокисления
веществ
субстрата,
сопровождающийся
выделением
и
запасением энергии.
• В процессе дыхания выделяются протоны
водорода и электроны.
22.
ТИПЫ ДЫХАНИЯАЭРОБНОЕ
ДЫХАНИЕ
акцептором водорода
или
электронов
служит молекулярный
кислород.
Анаэробное
дыхание
акцептором
служат
нитраты,
сульфаты,
фумарат
(только
бактерии)
Брожение
донорами
и
акцепторами
водорода являются органические
соединения.
По
конечному
продукту расщепления углеводов
различают
спиртовое,
молочнокислое, уксуснокислое и
другие виды брожения (только
бактерии и дрожжевые грибки).
23. Классификация бактерий по потребности в кислороде
ОБЛИГАТНЫЕ (ТРЕБУЮТ)(MICROCOCCUS LUTEUS)
ФАКУЛЬТАТИВНЫЕ
НЕ ТРЕБУЮТ, НО РАСТУТ ЛУЧШЕ
АЭРОБЫ
(ESCHERICHIA COLI)
МИКРОАЭРОФИЛЫ
ТРЕБУЮТ, НО В МАЛОЙ КОНЦЕНТРАЦИИ
(SPIRILLUM VOLUTANS)
М/О
АЭРОТОЛЕРАНТНЫЕ
(НЕ ТРЕБУЮТ, РОСТ НЕ СТИМУЛИРУЕТ
АНАЭРОБЫ
(STREPTOCOCCUS LACTIS)
ОБЛИГАТНЫЕ (УГНЕТАЕТ)
(CLOSTRIDIUM BOTULINUM)
24. Характер роста м/о на жидкой питательной среде в зависимости от потребности в кислороде
25. Создание газового состава
• Использование анаэростатов имикроанаэростатов
26. 3. Размножение и рост м/о
3.1. Размножение и рост бактерий• Большинство бактерий размножаются бинарным делением.
Грамотрицательные бактерии делятся путем перетяжки в
результате образования гантелевидных фигур, из которых
затем образуются две одинаковые клетки.
Грамположительные
бактерии
делятся
путем
врастания
синтезирующихся
перегородок
деления внутрь клетки.
Клетки расходятся в результате
действия аутолитических ферментов,
разрушающих
сердцевину
перегородки. Аутолиз при этом может
происходить
неравномерно:
делящиеся клетки на одном участке
остаются
связанными
частью
клеточной
стенки
в
области
перегородки деления. Такие клетки
располагаются под углом друг к
другу
(дифтерийные
коринебактерии).
27. Бинарное деление бактерий
• Грамотрицательныебактерии
Деление в результате
перетяжки
• Грамположительные
бактерии
Деление в результате
врастания перегородки
внутрь клетки
28. Бинарное деление бактерий
29.
Некоторые бактерии размножаются инымиспособами:
1. Почкованием (фотосинтезирующие
несерные бактерии, железобактерии)
2. С помощью конъюгации (неполного
полового процесса, энтеробактерии)
3. Спорами, фрагментацией мицелия
(актиномицеты).
30.
В лабораторных (производственных) условияхможно получить 2 типа культур бактерий:
• стационарные – клетки бактерий помещают в
питательную среду, в процессе роста культуры не
удаляют продукты обмена и не добавляют
питательные вещества – рост в чашках Петри.
• непрерывные – в процессе роста непрерывно
подают свежую питательную среду и удаляют
продукты обмены – рост в биореакторах.
31.
Количественная оценка роста культуры бактерийПараметры:
1. Концентрация клеток (клеток/мл)
2. Время генерации – промежуток времени, за который
число клеток удваивается.
3. Константа скорости деления – число удвоений в час.
4. Константа скорости роста.
32.
Существует две подхода к определениючисла клеток в конкретный момент:
1. ПРЯМЫЕ МЕТОДЫ (непосредственный
подсчет клеток под микроскопом в
счетных камерах или на фиксированных
мазках).
2. КОСВЕННЫЕ МЕТОДЫ (высевы на
плотные питательные среды, осаждение
на мембранных фильтрах, определение
биомассы, мутности суспензии, общего
белка,
поглощения
кислорода
и
выделения углекислоты).
33.
Приусловии
пополнения
питательного
субстрата и отведения токсических продуктов
обмена
бактерии
выращивают
в
непрерывной
культуре
в
специальных
биореакторах – турбидостатах и хемостатах.
С помощью этой
аппаратуры
культура бактерий
поддерживается в
логарифмической
стадии роста
34. Методы промышленного культивирования бактерий
• Микроорганизмы культивируют на жидкихпитательных
средах
в
аппаратах
(ферментерах, биореакторах) различной
емкости (от 2 л до 400 м3) при оптимальном
температурном
режиме
и
физикохимических условиях (рН, масс-обменные
характеристики),
поддерживаемых
автоматически.
• Время выращивания большинства бактерий
при определенных условиях составляет 1-3
сут. Из 1 т культуры за это время получается
примерно 50 кг биомассы.
Лабораторный хемостат
35. 3.2. Размножение вирусов
Размножение вирусов –репродукция, происходит
только в живой клетке .
Происходит по трем сценариям:
• Продуктивный (цитоцидный) тип – вирус в
зараженных клетках образует новое поколение
вирионов, клетка погибает.
• Абортивный – цикл репродукции прерывается,
новые вирионы не образуются, клетка выживает
• Интегративный
(вирогения) – интеграция
(встраивание) вирусной нуклеиновой кислоты в
виде провируса в хромосому клетки и их
совместное сосуществование.
36. Стадии репродукции вируса
1. адсорбциявирионов
на
клетке;
2. проникновение вирусов в
клетку;
3. депротеинизация
(«раздевание»)
вирусов,
высвобождение
вирусного
генома;
4. биосинтез
компонентов
вируса;
5. формирование
вирусной
частицы;
6. выход вирионов из клетки.
37. Адсорбция вируса на клетке
1 стадияАдсорбция вируса на клетке
• Взаимодействие поверхностных белков вируса со
специфическими рецепторами чувствительных
клеток.
• Тропизм вируса (греч. tropos – поворот,
направление) – способность избирательно
поражать определенные клетки. Не требует
энергетических затрат
• Множественность заражения: клетка содержит
около 500 000 рецепторов → на клетке могут
сорбироваться множество вирионов.
Процесс адсорбции не требует энергетических затрат и протекает в две фазы:
● ионное притяжение между вирусом и клеткой, взаимодействие носит
неспецифический характер;
● физическое прикрепление вирусной частицы к соответствующему
поверхностному рецептору (структурная гомология, комплементарность
специфических рецепторов).
38.
39. Проникновение вируса в клетку
2 стадияПроникновение вируса
в клетку
Несколько механизмов:
• Виропексис (рецепторный
эндоцитоз)
• Слияние оболочки вируса с
клеточной мембраной (при
наличии белка слияния)
• Трансмембранная пенетрация –
проникновение
непосредственно через ЦПМ
(простые вирусы)
40. Адсорбция и проникновение вируса в клетку
41. Депротеинизация
3 стадияДепротеинизация
• Клеточные ферменты → депротеинизация
(высвобождение внутреннего компонента вириона)
• теневая фаза (фаза эклипса) → вирус невозможно
выделить из культуры ткани
42. Биосинтез вирусных компонентов
4 стадияБиосинтез вирусных компонентов
• Биосинтез
вирусных
компонентов
–
дизъюнктивный
(от
лат.
disjunctus
–
разобщенный).
Параллельно
синтезируются
вирусные нуклеиновые кислоты и вирусные белки.
• Транскрипция → трансляция → белки вируса.
• Репликация (от лат. replicatio – повторение) синтез
вирусных нуклеиновых кислот (невозможна в
покоящейся клетке, ее переход в фазу деления
активирует экспрессию вирусных генов).
• У +РНК вирусов внутриклеточное размножение начинается с
трансляции, затем репликация и сборка вириона.
• У всех остальных вирусов размножение начинается с
транскрипции геномной нуклеиновой кислоты, затем – трансляция
вирусных
мРНК,
репликация
генома,
формирование
нуклеокапсида.
43. Репликация вирусных геномов
• Двунитевая ДНК –полуконсервативная
репликация.
• Однонитевая ДНК:
вначале образуется
репликативная форма
(«-» нить которой
служит матрицей для
синтеза «+» нити,
идентичной исходной
вирионной ДНК).
44.
Репликация вирусных геномовОднонитевая РНК: вРНК→кРНК→вРНК,
катализируется репликазой.
вРНК-РНК вириона исходная
+РНК
кРНК-РНК, синтезируемая в
клетке хозяина
комплементарная вирусной
–РНК
45.
РЕПЛИКАЦИЯ ВИРУСНЫХ ГЕНОМОВОднонитевая РНК
ретровирусов:
РНК→ДНК→РНК,
катализируется вирусным
ферментом - обратной
транскриптазой.
Двунитевая ДНК вируса
гепатита В: ДНК→РНК→ДНК,
катализируется клеточной
РНК-полимеразой и обратной
транскриптазой.
46.
5 стадия Формирование вирионов• Самосборка за счет гидрофобных,
ионных, водородных связей и
стерического соответствия
(пространственного раположения).
• В результате образуются
нуклеокапсиды.
47. Выход вирионов из клетки
6 стадияВыход вирионов из клетки
• Взрывной: из погибающей клетки
одновременно выходит большое
количество
вирионов
(простые
вирусы).
• Почкование:
нуклеокапсид
транспортируется
к
клеточным
мембранам, в которые уже встроены
вирусные белки → выпячивание
этих участков → отделение почки от
клетки в виде сложно устроенного
вируса (сложные вирусы).
48. Интегративный тип взаимодействия вируса с клеткой
• Вирогения – интеграция (встраивание)нуклеиновой кислоты вируса в геном
клетки
• Кольцевая двунитевая ДНК вируса
необходима для встраивания в хромосому
клетки
• Встроенная в состав хромосомы клетки
вирусная ДНК называется провирусом.
49.
ПОСЛЕДСТВИЯ ИНТЕГРАТИВНОГОВЗАИМОДЕЙСТВИЯ ВИРУСА С КЛЕТКОЙ
• Латентные инфекции с периодическими реактивациями
• Вирусная трансформация клеток→ развитие опухолей,
аутоиммунных и хронических заболеваний
• Персистенция (от лат. persisto – постоянно пребывать,
оставаться) вирусов в организме → персистентные вирусные
инфекции
50.
3.3. РАЗМНОЖЕНИЕ ПРОСТЕЙШИХПростейшие размножаются бесполым и половым способами.
При бесполом размножении ядро, а затем и цитоплазма делятся на две части. У
одних деление происходит вдоль, у других — поперек тела. У некоторых
сначала несколько раз делится ядро, а затем соответственно числу ядер
разделяется и цитоплазма.
Половое размножение простейших происходит также по-разному. Суть его
заключается в слиянии ядер и цитоплазмы двух различных организмов —
отцовского и материнского.
Многие простейшие имеют не одну, а несколько форм размножения, которые
могут закономерно чередоваться друг с другом. В результате получается
сложный цикл развития, отдельные части которого могут протекать в разных
условиях среды.
51.
3.4. РАЗМНОЖЕНИЕ ГРИБКОВСпособы размножения грибков
Половое
половые
клетки
соединяются, образуя
зиготу, которая затем
делится.
Образовавшаяся зигота
у дрожжевых грибков
трансформируется
в
«сумку»,
в
которой
заключены 4-8 спор
Бесполое
Вегетативное
В
бесполом
размножении основную
роль играют споры.
Споры
содержатся
внутри
особых
споровместилищ либо
на краях специальных
выростов грибницы –
конидиеносцах.
происходит отделение
от основы мицелия его
частей,
которые
способны
самостоятельно
существовать
(плесневые грибки).
У дрожжевых грибков
вегетативное
размножение
происходит с помощью
почкования
Бесполое размножение – главный способ размножения плесневых
грибов.
52. Вегетативное размножение грибков
• Плесневых• Дрожжевых
53. Половое размножение у дрожжей
54. Бесполое размножение у плесневых грибков
СПОРАНГИОСПОРЫ - (от спорангий и споры), споры бесполого
размножения, образующиеся в спорангии грибка. Лишены органов
движения. Прорастают вегетативной гифой мицелия.
КОНИДИЕСПОРЫ - неподвижные споры бесполого размножения у
грибков.
Они
являются
гаплоидными
клетками,
генетически
идентичными гаплоидным родительским. При благоприятных условиях
развиваются в новый организм и способствуют распространению, то
есть служат как для размножения, так и для расселения. От
спорангиоспор отличаются тем, что образуются не в спорангиях, а
открыто — на выростах мицелия.
ХЛАМИДОСПОРЫ - (от греческого chlamydos — плащ, мантия и споры),
споры некоторых грибов, образующиеся вегетативно при распадении
мицелия на отдельные клетки или иным путём. Имеют различную
форму, покрыты толстой оболочкой. Могут быть одиночными или в
цепочке. Возникают при неблагоприятных условиях, в том числе при
истощении питательных веществ в субстрате и служат для сохранения
гриба. Прорастают вегетативно мицелием.
55.
56.
57. ВЛИЯНИЕ НА МИКРООРГАНИЗМЫ ХИМИЧЕСКИХ и ФИЗИЧЕСКИХ ФАКТОРОВ
Методы стерилизации, дезинфекции,асептики и антисептики
58. 1. ВЛИЯНИЕ НА МИКРООРГАНИЗМЫ ХИМИЧЕСКИХ ФАКТОРОВ
1. Галогенсодержащие2. Фенолы
3. Альдегиды
4. Спирты
5. Кислоты
6. Перекиси
7. Соли тяжелых металлов
8. Красители
9. Поверхностно-активные
вещества
Вызывают денатурацию белков
(инактивацию ферментов, остановку
реакций метаболизма), разрушение
нуклеиновых кислот
Соединяются с каталитическим центром
ферментов, вызывают их инактивацию
и остановку реакций метаболизма
Изменяют заряд оболочки клетки,
нарушают проницаемость мембран
59. ГРУППЫ ХИМИЧЕСКИХ ВЕЩЕСТВ, ОБЛАДАЮЩИХ БАКТЕРИЦИДНЫМ И БАКТЕРИОСТАТИЧЕСКИМ ДЕЙСТВИЕМ
• 1) Хлорсодержащие (хлорактивные) вещества.• органической
(тозилхлорамид
натрия,
хлорпроизводные циануровой кислоты и гидантоина)
природы,
• неорганической
(гипохлориты,
пентагидрат
гипохлорита натрия) природы.
Многие хлорактивные препараты наряду с достоинствами имеют и ряд
недостатков (недостаточная растворимость, низкая стабильность,
резкий запах, способность раздражать слизистые оболочки глаз и
верхних дыхательных путей, вызывать коррозию металлических
поверхностей, разрушать и обесцвечивать ткани).
Хлорамин Б — порошок с содержанием 26% активного хлора
(используют 1, 3 и 5% растворы хлорамина. Добавление
активаторов (аммиака в соотношении 1 : 8 или солей аммония в
соотношении 1:1 и 1:2) повышает активность хлорамина.
Активированные растворы хлорамина применяют в более
низких концентрациях (0,25—1%).
60.
2) ПРОИЗВОДНЫЕ ФЕНОЛА.
3) АЛЬДЕГИДЫ.
Фенол,
или
кристаллическая
карболовая кислота, применяется в
виде 3-5% водных и мыльных
растворов.
Мыльно-карболовый
раствор приготовляют из расчета 3%
фенола в 2% растворе зеленого
мыла или 5% раствор фенола в 3%
мыльном
растворе.
Лизол — смесь чистых крезолов и
калийного мыла, более эффективен,
чем фенол (3—5% растворы лизола).
В последнее время бактерицидные
вещества
на
основе
простых
фенолов заменяют более активными
составами
на
основе
галоидированных
фенолов
или
алкилфенолов.
Отечественный
препарат
бензилфенол
—
40%
концентрат на зеленом мыле —
эффективен в отношении различных
бактерий, а также патогенных грибов.
Наиб.
распространены
формальдегид
и
глутаровый
альдегид. Формальдегид применяют
в виде формалина (40%-ный р-р) как
дезинфицирующее
и
дезодорирующее
средство
для
мытья рук, обработки кожи при
повышенной потливости (0,5—1%
растворы),
для
дезинфекции
инструментов
(0,5%
раствор),
обработки обуви и перчаток при
грибковых
заболеваниях
кожи.
Глутаровый альдегид (2%-ный р-р)
используют
для
стерилизации
изделий
из
резины
и
др.
полимерных материалов.
Для
влажной
дезинфекции
помещения формалин не применяют
из-за
раздражающего
запаха,
используют
для
дезинфекции
главным образом в газообразном
состоянии или для обработки вещей
в камерах.
61.
4)ПОВЕРХНОСТНО-АКТИВНЫЕ
ВЕЩЕСТВА.
По
способности ионизироваться в водных растворах их
разделяют на катионные, анионные, амфолитные и
неионогенные ПАВ. В качестве самостоятельных
дезинфектантов используют только катионные и
амфолитные ПАВ ( например, амфолан). Амфолитные
ПАВ имеют ряд преимуществ перед катионными — они
малотоксичны, действуют на бактерии, грибы и некоторые
вирусы, не утрачивают активности в присутствии жира и
белка, не коррозируют металлы. ПАВ всех других групп
применяют
как
полезные
добавки
в
составе
композиционных дезинфицирующих средств.
5) ЙОД, БРОМ И ИХ СОЕДИНЕНИЯ. Из соединений йода для дезинфекции
наиболее широко используются йодофоры (С−280, веладин, иозан, супердип,
дайазан и др.) — комплекс йода и носителя, представляющего собой
высокомолекулярное соединение и ПАВ.
Выраженное бактерицидное действие йодофоров обуславливает применение
этих веществ в основном в качестве антисептиков и очень ограниченно —
для дезинфекции отдельных объектов. Из йодофоров известны йодопирон
и йодонат, носителями йода в которых являются соответственно
поливинилпирролидон и сульфонат, повидон-йод (содержит 1% активного
йода). Для обеззараживания рук медицинского персонала на основе
повидон-йода созданы композиции с сульфонолом и неонолом.
62.
6) ПЕРЕКИСНЫЕ СОЕДИНЕНИЯ. Составы на основе пероксида (перекисиводорода) часто применяют при ликвидации кишечных и воздушно-капельных
инфекций (1-6%-ные р-ры с добавкой 0,5%-ного р-ра к.-л. моющего средства,
напр., сульфонола).
Для тех же целей предназначен гидроперит - комплексное соединение Н2О2 с
мочевиной (CO(NH2)2)• (1 таблетка соответствует 15 мл 3%-ного р-ра Н2О2; для
получения 1%-ного р-ра в 100 мл воды растворяют 2 таблетки). Она
соответствует многим требованиям: не пахнет, быстро разлагается во внешней
среде на нетоксичные продукты, не вызывает аллергизации, но вместе с тем
малостабильна, оказывает выраженное местнораздражающее и кожнорезорбтивное действие, имеет низкую (в сравнении с другими
дезинфицирующими средствами) бактерицидную активность. Композиционные
препараты пероксида - пероксикарбонат натрия (персоль), пероксид
карбамида (гидроперит, пероксоборат натрия). Композиции на основе перекиси
водорода в твердой и жидкой форме получили широкое признание (например,
аписин) ввиду высокой эффективности, широкого спектра действия,
небольшой токсичности, экологической безопасности и удобства в
применении.
63.
7) Кислоты, надкислоты и их соли. На основе надуксусной кислотыизвестны вофастерил и перстерил (содержание действующего
вещества
40%
и
20%
соответственно).
Эти
препараты
рекомендованы для дезинфекции изделий медицинского назначения
из стекла, металла, текстиля, резины, гигиенической и хирургической
обработки рук.
8) Спирты. В качестве дезинфицирующих средств (и антисептиков)
находят применение спирты. Их используют как самостоятельно, так
и в качестве растворителей, усиливающих активность других
дезинфицирующих средств. Спирты обладают бактерицидным и
вирулицидным свойствами. Для дезинфекции наиболее широко
применяют этиловый и изопропиловый спирты в концентрации 60–
90% (по объему).
64. 2. Стерилизация и дезинфекция
Стерилизация – полное уничтожение микробов в
объекте.
Достигается с помощью воздействия на м/о физическими и
химическими факторами или механическим очищением.
Физические факторы стерилизации: высокая температура
(денатурация белков), УФ излучение (нарушение структуры
нуклеиновых кислот), УЗ, рентгеновское и ионизирующе
излучение (нарушение структуры биомолекул).
Химические факторы – вещества, вызывающие нарушение
структуры белков, мембран, нуклеиновых кислот
(токсические газы).
Механическое очищение жидкостей от клеток м/о с помощью
фильтрования через фильтры с малым размером пор.
65.
МЕТОДЫ СТЕРИЛИЗАЦИИТепловые
Сухим
жаром
Паром под
давлением
Холодные
Открытым
пламенем
Токсичными
газами
Гаммаизлучением
Ультрафиол
етом
Фильтрован
ием
Тиндализация
(дробная)
Ультразвуком
Ультравысокотемпер
атурная
66.
67.
Самый надежный метод стерилизациилюбых материалов – автоклавирование
(паром под давлением)
68.
69.
70.
КОНТРОЛЬ СТЕРИЛИЗАЦИИ – косвенный, контрольработы стерилизаторов:
• Изменение окраски химических индикаторов, помещаемых на поверхности и
в глубине стерилизуемого объекта, вследствие воздействия высоких
температур
• Использование биотестов – культур термоустойчивых бактерий (Bac.
stearothermophilus), которые должны погибнуть в процессе стерилизации
Фарфоровый фильтр
Фильтр
бактериальновирусный
Силикатный фильтр
71.
ДЕЗИНФЕКЦИЯ – обработка загрязненного м/о предмета с цельюснижения
их
концентрации
до
такой
степени,
чтобы
использование данного предмета не могло вызвать инфекцию.
Дезинфицирующие средства — химические и физические средства,
применяемые
для
уничтожения
во
внешней
среде
возбудителей
инфекционных заболеваний человека, животных и болезней растений.
Физическими агентами, используемыми в качестве дезинфицирующих средств,
являются кипячение, высушивание, обработка паром, сухим горячим воздухом,
воздействие токами высокой частоты, ультразвуком, УФ лучами.
Химические дезинфицирующие средства, применяемые для уничтожения
патогенных микроорганизмов на предметах внешней среды, должны обладать:
хорошей растворимостью в воде,
вызывать гибель микробов в короткие сроки,
не снижать активности в присутствии органических веществ,
быть нетоксичными или малотоксичными для человека и животных,
не иметь резкого неприятного запаха и не портить обеззараживаемых
предметов.
Эти дезинфицирующие средства чаще применяют в виде растворов или
суспензий в определенных концентрациях, придерживаясь установленных
сроков действия.
72.
73. АСЕПТИКА И АНТИСЕПТИКА
Асептика – комплекс мероприятий, предотвращающих попадание в организмчеловека патогенных микроорганизмов и вирусов.
Включает:
• стерилизацию и сохранение стерильности всего, что соприкасается с раной
• использование специальной одежды, масок
• планировка операционных и перевязочных
Антисептика – комплекс мероприятий по уничтожению микроорганизмов в
ране, патологическом очаге и организме в целом, предупреждение или
ликвидацию воспалительного процесса. Включает методы:
• механические (удаление инф. тканей)
• физические (дренированеи ран)
• химические (применение антисептиков)
• биологические (применение ферментов, бактериофагов, антибиотиков)
Антисе́птики отличаются от дезинфектантов чисто формально: первые
применяют для антимикробной обработки поверхности человеческого тела или
его полостей, вторые — для окружающих предметов или выделений больного.
И те и другие обладают широким спектром действия и активны в отношении
бактерий, бацилл, простейших, грибов.

biology
biology








